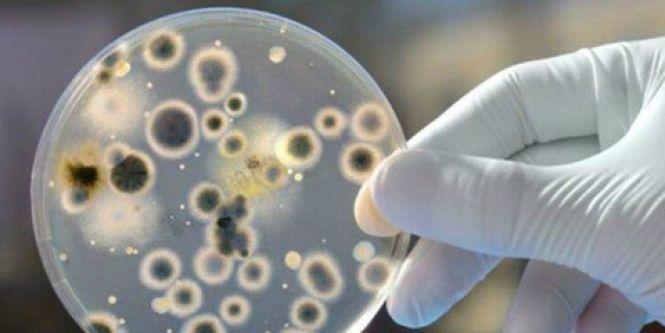
Панацеї ще не придумали: як врятуватись від осінньої алергії, фото №1 на сайті vsim.ua

Панацеї ще не придумали: як врятуватись від осінньої алергії
-
Алергія - хвороба 21 століття
-
Осінь - один із проблемних періодів
-
Що це таке і як з цим боротися?
Найважчим сезоном для алергіків варто вважати весну. Цвітіння дерев та квітів, пилок плодоносних рослин завдають людям з підвищеною чутливістю колосального дискомфорту. Однак, алергія мучить людство не лише навесні. Осіння пора тому не виняток.
Запаморочення, втрата смаку, сльозовиділення та нежить - якщо від наведених симптомів у вас панічно виникає питання “Може, у мене коронавірус?”, то припиніть. Можливо, ви просто потерпаєте від сезонної алергії.
Що може стати причиною алергії восени
Насправді, причин для осінньої алергії не менше, аніж навесні. Бо, як виявилось, не лише пух та пилок провокує алергенний організм на нежить та сльози.
Бур’ян
Ці рослини викликають не лише неприємні асоціації у бабусь, які вирощують на своїх городах овочі. Найпоширеніші бур’яни - це амброзія та лобода, які починають квітнути у середині серпня, і цвітуть до кінця вересня. У міських зонах пилок із цих рослин може поширюватись сотнями кілометрів. Часом вистачить легенького вітерця, який піднесе пилок на висоту, достатню для вдиху людини. В результаті - нежить та підвищене сльозовиділення.
Цвіль
Осіння пора - період знижених температур та підвищеної вологості. Волога - улюблене місце для життя цвілі. Особливо така проблема актуальна для мешканців старих будинків, в яких інколи протікає дах та труби. Цвіль пристосовується майже до усіх умов життя: на шпалерах, на ізоляційних матеріалах, килимах, гіпсокартоні тощо - головне аби було волого та сиро.
Та не лише домашня цвіль небезпечна для здоров’я. Холодна погода змушує опадати листя з дерев, яке під впливом низьких температур та вологи пріє та розкладається. Саме опале листя також є місцем, де швидко розвиваються та розмножуються спори цвілі. Достатньо лише вдихнути осіннього повітря після дощу.
Будь-яка цвіль (домашня чи вулична) викликає у алергіків нежить, утруднення дихання, а інколи навіть бронхіальну астму.
Пиловий кліщ
Також осінь - період, коли члени родини більше часу проводять вдома. Як результат - більше квартирного пилу, де знайшли для себе прихисток пилові кліщі. 
Харчові продукти
Знижений імунітет - ще одна типова для осені риса. Зменшення вітаміну D, постійна сльота та погане самопочуття стає причиною поступового послаблення роботи імунної системи, яка згодом і перестає допомогати організму опиратись алергії. Результат - цитрусові, горіхи та молочні продукти, які раніше ви споживали спокійно, можуть дати алергічну реакцію.
Як протистояти алергії
Алерголог Катерина Хайдакіна розповідає, що панацеї, яка би врятувала всіх від алергії, ще не винайшли.
-
Єдине, що можна зробити, це уникати речей, які викликають у вас алергічну реакцію. Наприклад, щодо вуличної цвілі. Так як у країні досі діє масочний режим, окрім COVID-19 ми ще й можемо врятуватись від спор цвілі.
-
Вдома ми тепер проводимо трохи більше часу, особливо ввечері. Регулярне прибирання та провітрювання квартири допоможе полегшити ситуацію.
-
Обов’язково потрібно їсти більше вітамінів. Хоча осінь - період зниження імунітету, природа цієї пори подарувала нам купу поживних речовин у вигляді фруктів та овочів.
-
Якщо справлятись із алергією вже немає сил - зверніться до свого сімейного лікаря. Він випише вам антигестамінні препарати, які полегшать погане самопочуття та хоч трохи врятують від нав’язливих симптомів у вигляді сльозовиділення, чхання, нежиті тощо.
А ви стикались із проблемою осінньої алергії?
Слідкуйте за новинами Хмельницького у Telegram.
-
Ірина БортюкЦе теж короновірус -
Нелякожен вечір і ніч дим, яка алергія....здоровим нема чим дихати